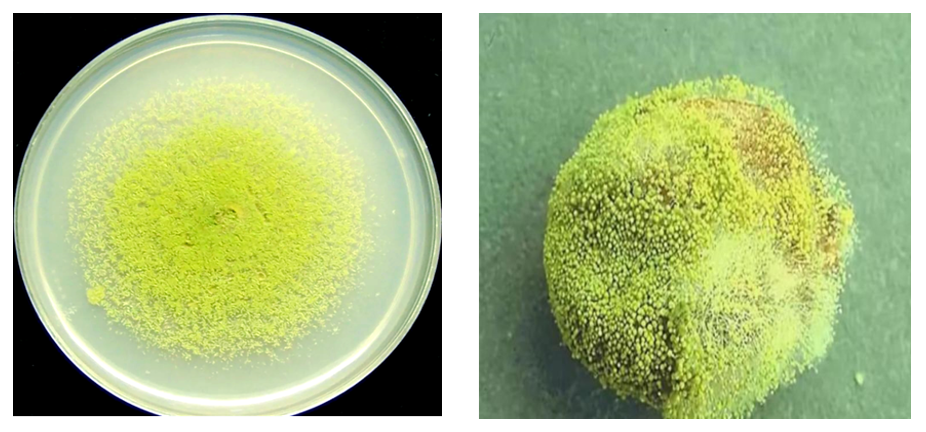

作为毒性达到砒霜68倍的一级致癌物,很多人对黄曲霉毒素并不陌生。在日常生活中,由于它是污染农产品与食品最常见的真菌毒素之一,往往容易成为藏在餐桌上的“食物刺客”。

“省出来的癌”!你家厨房可能也有→
作为毒性达到砒霜68倍的一级致癌物,很多人对黄曲霉毒素并不陌生。
在日常生活中,由于它是污染农产品与食品最常见的真菌毒素之一,往往容易成为藏在餐桌上的“食物刺客”。
60岁女子5年不换筷子胃里发现黄曲霉菌
7月28日,郑州一60岁女子因为呕吐、腹泻前往医院就医,医生在她胃中发现大量黄曲霉菌。据了解,该女子平时生活十分节省,一双筷子用了5年都没有更换,医生高度怀疑与此有关。好在经过治疗,该女子已经康复出院。
医生提醒:黄曲霉毒素具有强烈致癌性,但是筷子本身并不会生长黄曲霉菌,木质餐具长期使用不可避免留下食物残渣,可能会导致霉变,建议定期更换木质餐具。
女子劈开用几年的菜板满是黄曲霉素
此前,河南一女子发视频表示,自己劈开家中用了几年的菜板子,发现里面的材质是拼接的,且已经全部发霉变质,“黄曲霉素窝”被揪出!吓得赶紧扔掉,买了一块新的实木案板。

▲来源:人民日报
这样的“切菜板藏毒”的事件,此前也曾多次被报道:北京一位女士被检查出患有癌症,更可怕的是,她的爸爸、哥哥等一家四口全都相继患癌去世。研究人员进行了大量的分析实验,发现厨房里不起眼的菜板——黄曲霉菌超标了。

1毫克就可能导致癌症发生!你家厨房里可能也有
1毫克黄曲霉毒素就可能导致癌症(尤其是肝癌)的发生,其毒性是砒霜的68倍,被世界卫生组织划定为一级致癌物。
解放军总医院第八医学中心营养科主任医师左小霞称,黄曲霉毒素是黄曲霉菌的代谢产物,280℃以上的高温才能杀灭。
黄曲霉菌喜欢藏在发霉变质的食物或发霉的物品中:
过期或变质的食用油;霉变的坚果、大豆;发霉的玉米、小麦、大麦等;久泡变质的木耳;发霉的茶叶;发霉的筷子、案板等。
此外,潮湿的土壤、湿度较高的农田或储藏不当的谷物库房、潮湿的地下室、浴室、厨房、发霉的木材、墙壁、地板等都可能成为黄曲霉菌滋生的场所。

食物煮沸后仍无法消除
黄曲霉毒素分子结构稳定,耐高温(熔点为237℃~299℃),一般的烹调加工温度下很难被破坏。此外,变质食物中含有的毒素大部分不能通过高温来降低或消除,如黄曲霉毒素和米酵菌酸等,这些物质的耐热性都很强。
日常生活中如何预防和远离黄曲霉菌?
注意食品卫生:
1、购买食材时,选择外观健康、无霉斑的食物;
2、将食品存放在干燥、通风良好的环境中,避免潮湿和高温环境,可以减少黄曲霉菌滋生。
3、遵循食品的保质期和储存要求,及时食用或处理即将过期的食品。
4、避免食用明显霉变的食物,如果食物表面有霉斑,最好将其全部丢弃,吃到变苦的瓜子等坚果,一定要及时吐掉并且漱口。
5、食品储存区域以及餐具要定期清洁和消毒。
注意环境卫生:
1、保持室内空气流通,避免潮湿和高湿度的环境,因为这些条件有利于黄曲霉菌的生长。
2、定期检查房屋和建筑物的潮湿、漏水问题,及时修复和清理可能滋生黄曲霉菌的地方。
快转发分享到“相亲相爱一家人”群
让家人远离「省出来的癌」!
来源:北京交通广播


